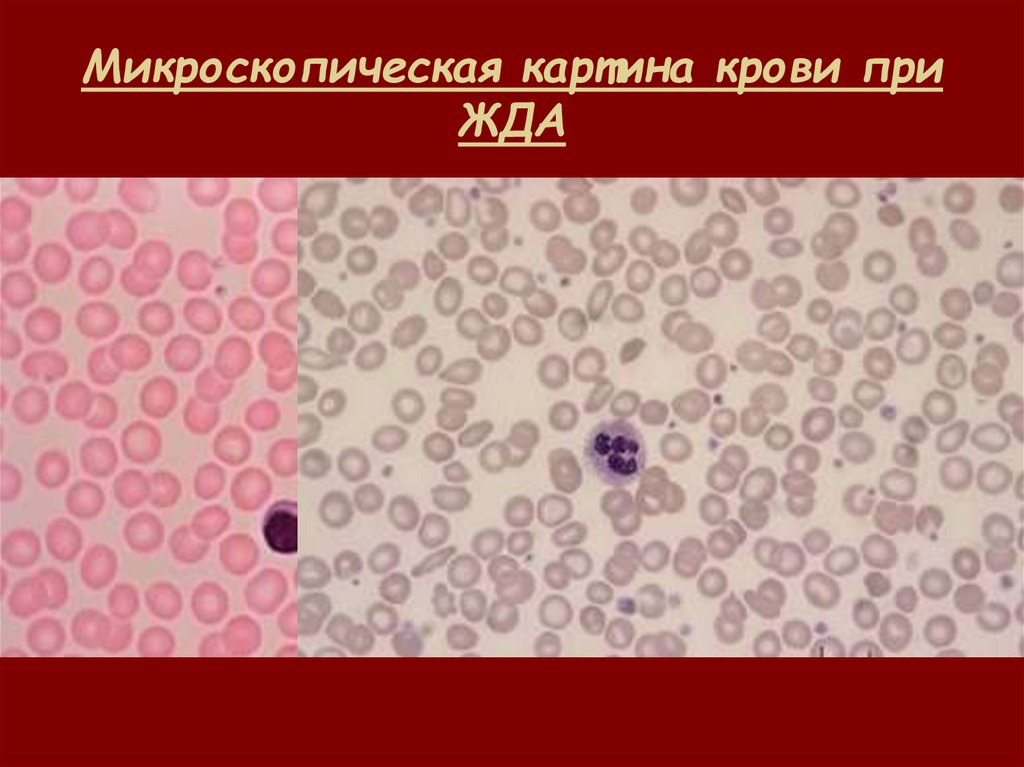

Similar presentations:
Основные принципы диагностики анемий
1.
ОСНОВНЫЕ ПРИНЦИПЫДИАГНОСТИКИ АНЕМИЙ
2.
• АНЕМИЯ – клинико-лабораторныйсиндром, характеризующийся
снижением уровня гемоглобина,
эритроцитов и гематокрита в единице
объема крови
3.
Критерии анемии (ВОЗ):для мужчин:
• уровень гемоглобина <130 г/л
• гематокрит менее 39%;
для женщин:
• уровень гемоглобина <120 г/л
• гематокрит менее 36%;
для беременных женщин:
• уровень гемоглобина <110 г/л
4. Клинико-патогенетическая классификация анемий: классификация D.Natan; F.Oski, 2003 г.
• I. Анемии, обусловленные ост ройкровопот ерей
• II. Анемии, возникающие в результ ат е
дефицит ного эрит ропоэза
• III. Анемии, возникающие в следст вие
повышенной дест рукции эрит роцит ов.
• IV.* Анемии, развивающиеся в результ ат е
сочет анных причин;
5. II. Анемии, возникающие в результате дефицитного эритропоэза
1) За счёт нарушенного созревания (микроцит арные):Железодефицитные;
Нарушение транспорта железа;
Нарушение утилизации железа;
Нарушение реутилизации железа;
2) За счет нарушения дифференцировки эрит роцит ов;
А/гипопластическая анемия (врожденная, приобрет.)
Дизэритропоэтические анемии;
3) За счет нарушения пролиферации клет окпредшест венниц эрит ропоэза (макроцит арные);
В12-дефицитнве;
Фолиево-дефицитные;
6. III. Анемии, возникающие в следствие повышенной деструкции эритроцитов
1)Приобрет енный гемолиз (неэрит роцит арные причины):• Аутоиммунный;
• Неиммунный (яды, медикаменты, и др.)
• Травматический (искусственные клапаны, гемодиализ);
• Клональный (ПНГ);
2) Гемолиз, обусловленный аномалиями эрит роцит ов:
• Мембранопатии;
• Ферментопатии;
• Гемоглобинопатии;
3) Гиперспленизм – внут риклет очный гемолиз
(сначала снижает ся уровень т ромбоцит ов, анемия
развивает ся позже);
7. Клиническая картина анемии:
• 1. Анемический синдром• 2. Синдром гемолиза;
• 3. Синдром неэффективного эритропоэза;
• 4. Синдром дизэритропоэза;
• 5. Синдром сидеропении;
• 6. Синдром гиперспленизма;
• 7. Синдром перегрузки железом;
8. Анемический синдром
• Проявления зависят от глубиныанемии и скорости ее развития;
• Слабость; утомляемость;
• Снижение, извращение аппетита;
• Одышка; сердцебиение;
• Головокружение;
• Шум в ушах, мелькание «мушек»;
• Обмороки;
• Утяжеление приступов стенокардии;
9. Синдром гемолиза;
• ПРИЧИНЫ: дефект ы оболочки эрит роцит ов;дест рукция ант ит елами; внут риклет очная
дест рукция; неиммунное повреждение…
• КЛИНИКА: желт ушное окрашивание склер,
кожи, т ёмная моча, увеличение печени и
селезенки;
• ЛАБОРАТОРИЯ: возможно снижение НЬ и
эрит роцит ов, увеличение СОЭ;
рет икулоцит оз, повышение непрямого
билирубина и ЛДГ (4-5), уробилиноген в
моче,ст еркобилин в кале;
• Миелограмма: раздражение эрит роидного
рост ка
10. Синдром неэффективного эритропоэза
• сост ояние, при кот ором акт ивност ь кост ного мозгаувеличена, но выход созревших эрит роцит ов в кровь
снижен из-за повышенного разрушения в кост ном
мозге эрит робласт ов.
КЛИНИЧЕСКИЕ СИТУАЦИИ:
• тяжелая анемия вне зависимост и от причин;
• анемия при хронических болезнях;
• некот орые формы наследст венных анемий;
• Клональные анемии (ПНГ, МДС)
СИМПТОМЫ: возможно развит ие кост ных
деформаций при длит ельном сущест вовании
вследст вие расширения плацдарма кровет ворения
11. Синдром дизэритропоэза
• Морфологические признаки нарушенногосозревания эритроцитов в костном мозге,
косвенное указание на существующий
неэффективный эритропоэз (многоядерные
эритробласты, дольчатые ядра, хроматиновые
мостики, кариорексис).
КЛИНИЧЕСКИЕ СИТУАЦИИ: МДС, тяжелые
формы любых анемий, мегалобластные
анемии, талассемия, сидеробластные анемии;
КЛИНИКА: нетяжелый гемолиз, сопутствующий
другим признакам анемии
12. Синдром сидеропении и состояние латентного дефицита железа
• Дистофия кожи и её придатков;• Извращение вкуса и обоняния;
• Мышечная гипотония (недержание
мочи);
• Мышечные боли,
• Снижение внимания;
• Ухудшение памяти и т.д.
13. Синдром гиперспленизма
• Сочет ание увеличенных размеров селезенки сповышенной клет очност ью кост ного мозга и
цит опеническим сост оянием периферической крови.
КЛИНИЧЕСКИЕ СИТУАЦИИ:
• Венозный застой, внепеченочная портальная
гипертензия;
• Клеточная инфильтрация селезенки при опухолевых
процессах и лимфопролиферативных состояниях;
• Саркоидоз;
• Амилоидоз;
• Экстрамедуллярное кроветворение;
• Болезнь Гоше;
• Инфекции (СМВ, токсоплазмоз) и др.
14. Синдром перегрузки железом;
ПРИЧИНЫ:• Повышенное всасывание;
• Дополнительное введение;
• Трансфузии эр.массы;
• Образование железа при усиленной
гибели клеток;
ПОСЛЕДСТВИЯ: гемосидероз
внутренних органов
15.
ОСНОВЫЛАБОРАТОРНОЙ
ДИАГНОСТИКИ
АНЕМИЙ
16. Основные показатели красной крови и эритроцитарные индексы
RBCRed Blood Cells
Количест во эрит роцит ов
Hb
Hemoglobin
Гемоглобин
Ht
Hematocrit
Гемат окрит
MCV
Mean Cell Volume
Средний объём эрит роцит а
MCH
Mean Corpuscular Hemoglobin
Среднее содержание
гемоглобина в одном эрит роцит е
MCHC
Mean Corpuscular Hemoglobin
Concentration
Средняя концент рация
гемоглобина в эрит роцит ах
CHCH*
Mean Cellular Hemoglobin
Concentration
Средняя клет очная концент рация
гемоглобина
RDW
Red Distribution Width
Ширина распределения
эрит роцит ов по объёму
HDW*
Hemoglobin Distribution Width
Ширина распределения
эрит роцит ов по концент рации
гемоглобина
17.
• АНИЗОЦИТОЗ – увеличение доли эрит роцит овразного размера в мазке крови. Эт от
показат ель характ еризует ся RDW;
• Микроцит ы – эрит роцит ы, чей диамет р при
подсчет е в мазке, менее 6,5 мкм;
• Шизоцит ы – эрит роцит ы диамет ром менее 3
мкм, а т акже обломки эрит роцит ов;
• Макроцит ы – большие эрит роцит ы диамет ром
более 8 мкм, с сохраненным просвет лением в
цент ре;
• Мегалоцит ы – гигант ские эрит роцит ы
диамет ром более 12 мкм без просвет ления в
цент ре.
18.
• ПОЙКИЛОЦИТОЗ – увеличение количест ваэрит роцит ов различной формы в мазке крови.
Имеют дифференциально-диагност ическое
значение:
• Сфероцит ы, овалоцит ы, ст омат оцит ы,
серповидные клет ки
Определяют ся при широком спект ре пат ологии:
• Мишеневидные эрит роцит ы, акант оцит ы,
дакриоцит ы, шизоцит ы, эхиноцит ы
19. Нормальные показатели гемограммы
Показат ельМужчины
Женщины
Гемоглобин г/л
130-160
120-140
Эрит роцит ы млн/мкл
4,0 - 5,1
3,7 – 4,7
Гемат окрит %
40 - 48
36 - 42
0,86 – 1,05
0,86 – 1,05
MCV, фл
80 - 95
80 – 95
MCH, пг
25 - 33
25 – 33
МСНС, г/л
30 - 38
30 – 38
RDW, %
11,5 – 14,5
11,5 – 14,5
2 - 15
2 - 15
Цвет овой показат ель, ед.
Рет икулоцит ы,
*/оо
20. РАСЧЁТ ЭРИТРОЦИТАРНЫХ ИНДЕКСОВ
• Ht (л/л; %) = RBC x MCV12
• MCV (фл) = Ht (л/л) х 1000/RBC x 10
12
• MCH ((пг) = Нb (г/л) / RBC x 10
• MCHC (г/л) = Hb (г/л) / Ht (л/л)
• RDW (%) = SD / MCV x 100
Где SD – ст андарт ное от клонение
• ЦП = 3хHb/RBC*
* 3 первые цифры показат еля RBC
21. Возможные причины ложно заниженных результатов
HtМикроцит оз, гемолиз in vitro; аут оагглют инины
RBC
Холодовые агглют инины; т ромбообразование;
MCV
гемолиз in vitro; фрагмент ация эрит роцит ов
MCH
MCHC
WBC > 50 т ыс/мл
WBC
WBC > 70 т ыс/мл
Plt
Наличие т ромбоцит арных агглют ининов,
использование гепарина
22. Возможные причины ложно завышенных результатов
HtКриопротеины, гигантские тромбоциты,
WBC > 50 тыс/мл; гипергликемия
RBC
WBC > 50 тыс/мл
гиперлипидемия
MCV
WBC > 50 тыс/мл, аутоагглютинины, ретикулоцитоз,
диабетический кетоацидоз; гиперлипидемия, отравление
метанолом
MCH
WBC > 50 тыс/мл, холодовые агглютинины; гемолиз in vivo;
моноклональные протеины в крови; липидемия; гипергликемия;
высокая концентрация гепарина
MCHC
холодовые агглютинины; гемолиз in vivo; аутоагглютинины;
высокая липидемия; высокая концентрация гепарина, нарушения
калибровки прибора
WBC
Наличие криоглобулинов, агрегация тромбоцитов, присутствие
ядерных красных клеток
Plt
Наличие микроцитарных форм эритроцитов
23. Оценка тяжести анемии
• Лёгкой степениHb 110 – 90 г/л
• Средней степени
Hb 90 – 70 г/л
• Тяжелая анемия
Hb < 70 г/л
24. Морфологические варианты анемии
Микроцит арнаяНормоцит арная
Макроцит арная
MCV < 75 фл
MCV 75-95 фл
MCV > 95 фл
Гипохромная
Нормохромная
Гиперхромная
MCH < 24 пг
MCH 24-34 фл
МCH > 34 пг
MCHC < 30 г/л
MCHC 30-38
г/л
MCHC > 38 г/л
25. Дифференциальный диагноз анемий
26. Дифференциальный диагноз анемии в зависимости от количества ретикулоцитов
Повышение числарет икулоцит ов
Регенерат орные анемии
Rt = 1,5-5%
Гиперрегенерат орные
анемии Rt > 5%
•Мембранопатии эритроцитов;
•Ферментопатии эритроцитов;
•Гемоглобинопатии;
•Промежуточная форма
талассемии;
•ТМАГА;
•АИГА
Понижение числа
рет икулоцит ов
Гипо/арегенерат орные
анемии Rt < 0,5%
Рет икулоцит оз не
соот вет ст вует т яжест и анемии
•В12/фолиево-дефицитная анемия;
•Апластическая анемия;
•ЖДА 3 степени;
•ВДА;
•Большая форма талассемии;
•СБА;
•ПНГ
27. Анемия, обусловленные острой кровопотерей - острая постгеморрагическая анемия
СТАДИИ:1)рефлект орно-сосудист ая компенсация
Первые сут ки – лейкоцит оз (20 т ыс/мл) с
нейт рофильным сдвигом; гиперт ромбоцит оз (до
1 млн/мл).
2) гидремическая компенсация – снижение НЬ, Ht
и эрит роцит ов, возможен гемолиз, азот емия;
3) кост номозговая компенсация: повышение Эпо,
гиперплазия эрит роидного рост ка в кост ном
мозге, рет икулоцит оз, пойкилоцит оз,
полихромазия, нормобласт оз
28. Железодефицитная анемия (ЖДА)
• Полиэтиологичное заболевание,развивающееся в результате снижения
общего количества железа в организме
и характеризующееся прогрессирующим
микроцитозом и гипохромией
эритроцитов.
29. Морфологическая характеристика эритроцитов при ЖДА
Микроцит арнаяMCV < 75 фл
Гипохромная
MCH < 24 пг
MCHC < 30 г/л
Нормо- или
гипорегенерат орная
Rt 0,5 – 1 %
Возможен т ромбоцит оз на ранних эт апах
30. Микроскопическая картина крови при ЖДА
31. Синдром сидеропении и состояние латентного дефицита железа
• Дистофия кожи и её придатков;• Извращение вкуса и обоняния;
• Мышечная гипотония (недержание
мочи);
• Мышечные боли,
• Снижение внимания;
• Ухудшение памяти и т.д.
32. Внешний вид при сидеропении
33. Изменения кожи при сидеропении
34.
35.
36.
ГЛОССИТ37. Изменения ногтей при сидеропении
КОЙЛОНИХИИ38. Наиболее частые причины ЖДА
• Алиментарный дефицит железа (диеты,вегетарианство, недоедание);
• Повышение потребности в железе (частые
роды, многоплодная беременность; лактация;
быстрый рост; интенсивные занятия спортом;
недоношенность);
• Кровопотеря (носовые кровотечения,
диафрагмальная грыжа; дивертикул, полип
или опухоль ЖКТ; метроррагии; синдром
Гудпасчера);
• Снижение абсорбции (мальабсорбция;
воспалительные процессы в кишечнике;
ахлоргидрия; гастрэктомия)
39.
40. Показатели обмена железа при ЖДА
Сыворот очное железоСЖ
12,5-30 нг/мл;
↓↓
Общая
железосвязывающая
способност ь сыворот ки
ОЖСС
45-62,2
мкмоль/л
> 60
мкмоль/л
30 – 300 нг/мл
↓↓↓
↓↓
Феррит ин сыворот ки
Насыщение т рансферрина
железом
НТЖ
Раст воримые
трансфериновые
рецепт оры
рТФР
25 – 45 %
↑
41. Принципы лечения ЖДА
• Устранение причины железодефицита, если этовозможно;
• Препараты железа, доза которых
рассчитывается исходя из содержания
атомарного железа: 200-300 мг железа в сутки
за 3 приёма натощак;
• Первые 3 дня – 50% дозы;
• Контроль лабораторных показателей через 7-10
дней (Rt) и каждый месяц (СЖ, ФС);
• Прием поддерживающей дозы после
нормализации показателей;
• Общая продолжительность лечения 4-6
месяцев.
42. Некоторые препараты для лечения ЖДА
ГемоферАкт иферрин
Сульфат железа
драже
105 мг
Сульфат
капсулы
железа+серин
Гидроокись
таблетки
железа+фолиевая
кислота
Глюконат железа и Питьевой
микроэлементы
раствор
Гидроокись железа таблетки
34,5 мг
Ферроплекс
Сульфат железа +
аскорбин. кислота
Драже
10 мг
Тардиферон
Сульфан железа +
аскорбин.кислота
таблетки
51 мг
Мальт оферФол
Тот ема
Феррум-Лек
100 мг
50 мг
100мг
43. Передозировка препаратов железа
• КЛИНИКА: боли в эпигаст рии, т ошнот а,кровавая рвот а, диарея, загруженност ь,
бледност ь, цианоз, судороги, кома, анурия,
возможна смерт ь через 3-5 дней;
• ЛАБОРАТОРНЫЕ ПОКАЗАТЕЛИ:
мет аболический ацидоз, лейкоцит оз;
АУТОПСИЯ: некрозы почек и печени через 2 дня
ЛЕЧЕНИЕ:
вызват ь рвот у, промыт ь желудок, дат ь выпит ь
молоко или сорбент ,
госпит ализация: в/в инфузия десферала
(дефероксамин).
44. Анемии при хронических заболеваниях
• Вторичные состояния, развивающиесяпри длительно текущих инфекционных,
воспалительных, системных и
онкологических заболеваниях и
сопровождающиеся сниженной
продукцией эритроцитов и нарушенной
реутилизацией железа.
45. Нозологические формы, сопровождающиеся развитием АХЗ
1. Инфекции (т уберкулёз,бронхоэкт ат ическая болезнь,
эндокардит ы, бруцеллёз);
2. Злокачест венные опухоли;
3. Сист емные заболевания соединит ельной
ткани (РА, СКВ);
4. Хронические заболевания печени,
кишечника;
5. Болезни почек, сопровождающиеся ХПН
46. Патогенез АХЗ
• 1) Нарушение метаболизма железа;• 2) Супрессия эритропоэза;
• 3) Неадекватная прдукция Эпо;
• 4) Гемолитический процесс;
47. Принципы коррекция АХЗ
• Лечение основного заболевания;• Назначение эритропоэтина (150-500
МЕ/кг 2-3 раза в неделю);
• Трансфузии эритроцитарной массы;
• Назначение витаминов группы В;
48. Мегалобластные анемии
• Группа заболеваний,характеризующаяся специфическими
изменениями клеток крови и костного
мозга в результате нарушения синтеза
ДНК, вызванного недостатком
витамина В12 (болезнь АддисонаБирмера, пернициозная анемия) или
фолиевой кислоты
49. Микроскопическая картина крови при пернициозной анемии
50. Морфологическая характеристика эритроцитов при МБА
Макроцит арнаяMCV > 100 фл
Гиперхромная
MCH > 100 пг
MCHC > 36 г/л
Гипорегенерат орная
Rt < 0,5 %
ВОЗМОЖНО:
Лейкопения, сдвиг «вправо», гиперсегмент ация ядер
нейт рофилов, умеренная т ромбоцит опения.
51. Основные причины развития МБА
Дефицитвит амина В12
Недостаточное питание
Быстрый рост
Гемодиализ
Недоношенность
(редко)
Вскармливание козьим
молоком
Острые инфекции
Беременность
Ранний возраст
Лактация
Хрон. гемолиз
Беременность
Лактация
Целиакия
Врожд.дефицит
Заболевания тощей кишки
внутр.ф.Кастла
амилоидоз
Гастрэктомия
Алкоголизм
С.Золлингера-Эллисона Лимфома, целиакия
Панкреатит
Дефицит
Б.Крона
дигидрофолатредуктазы
Резекция кишечника
Др.нарушения метаболизма
фолатов
Глисты и др.
Неадекват ное Строгая вегетарианская
пост упление диета
Увеличенная
пот ребност ь
Нарушения
абсорбции
Дефицит
фолиевой кислот ы
52. Лекарственные препараты, приём которых приводит к развитию МБА
• Ингибит оры дегидрофолат редукт азы(метотрексат; сульфасалазин; аминоптерин; прогуанил;
триметоприм; триамтерен);
• Ант имет аболит ы (6-меркаптопурин; 6-тиогуанин;
азатиоприн; ацикловир; 5-фторурацил; зидовудин);
• Ингибит оры редукт азы РНК (цитозар;
гидрокссимочевина);
• Ант иконвульсант ы (дифенил; фенобарбит ал);
• КОК
• ДРУГИЕ (мет формин; неомицин; колхицин)
53. Клиническая картина:
• 1. Анемический синдром;• 2.Желудочно-кишечные нарушения
(анорексия, глоссит, снижение секреции в желудке);
• 3. Неврологические симптомы (В12)
(парестезии, гипорефлексия, нарушения походки и др.)
• 4. Синдром неэффективного эритропоэза;
• 5. Синдром дизэритропоэза;
54. Принципы лечения МБА
• Полноценное пит ание; дегельминт изация;• Вит амин В12 (цианкобаламин) 200-400
мкг 1 раз в сут ки в/м 4-5 недель;
• Динамика лаборат орных показат елей:
рет икулоцит арный криз на 5-8 день;
• Пожизненные поддерживающие дозы
вит амина В12 (200-400 мкг в месяц);
• Эр.масса по жизненным показаниям;
• Фолиевая кислот а: 5-10мг/сут ки в
течение 3-4 месяцев. Приём
поддерживающих доз.

medicine
medicine








